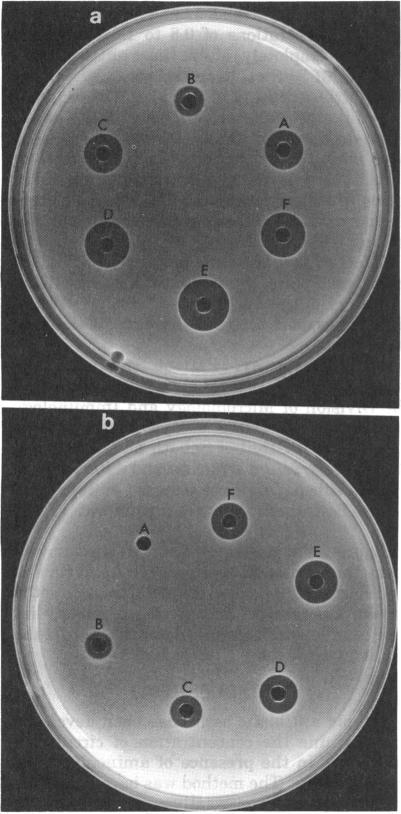
https://cdn.ncbi.nlm.nih.gov/pmc/blobs/aa49/429545/8a3a55cfddca/aac00309-0064-a.jpg

在快速血药浓度抗生素检测中使用聚茴香脑磺酸钠选择性抑制氨基糖苷类和多粘菌素类抗生素。
Use of sodium polyanethol sulfonate to selectively inhibit aminoglycoside and polymyxin antibiotics in a rapid blood level antibiotic assay.
作者信息
Edberg S C, Bottenbley C J, Gam K
出版信息
Antimicrob Agents Chemother. 1976 Mar;9(3):414-7. doi: 10.1128/AAC.9.3.414.
Sodium polyanethol sulfonate inhibits aminoglycoside and polymyxin classes of antibiotics in direct proportion to its concentration. Aminoglycoside and polymyxin class antibiotics are selectively inactivated; penicillin, including the semisynthetic penicillins, cephalothin, chloramphenicol, clindamycin, tetracycline, erythromycin, and vancomycin are not inhibited. By incorporating sodium polyanethol sulfonate directly into the test medium it is possible, in a 4-h antibiotic blood level assay, to selectively obviate the activity of the aminoglycosides and polymyxins to determine the concentration of other antibiotics present in the same serum sample.
聚茴香脑磺酸钠抑制氨基糖苷类和多粘菌素类抗生素的作用与其浓度成正比。氨基糖苷类和多粘菌素类抗生素被选择性灭活;青霉素(包括半合成青霉素)、头孢噻吩、氯霉素、克林霉素、四环素、红霉素和万古霉素则不受抑制。通过将聚茴香脑磺酸钠直接加入测试培养基中,在4小时抗生素血药浓度测定中,有可能选择性消除氨基糖苷类和多粘菌素的活性,以测定同一血清样本中其他抗生素的浓度。